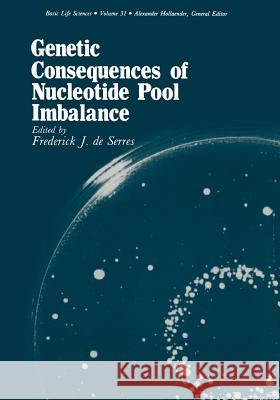
Genetic Consequences of Nucleotide Pool Imbalance Frederick D 9781461294887 Springer - książka

Genetic Consequences of Nucleotide Pool Imbalance » książka
Genetic Consequences of Nucleotide Pool Imbalance
ISBN-13: 9781461294887 / Angielski / Miękka / 2011 / 523 str.
This book is concerned with the genetic consequences of nu cleotide pool imbalance. There are a number of ways in which this state can be achieved and the majority of papers in this volume de scribe the effects of nucleotide pool imbalance on DNA replication and repair, and the induction of gene mutations in various organisms. This book grew out of a Conference on "Genetic Consequences of Nu cleotide Pool Imbalance" which was held at the National Institute of Environmental Health Sciences on May 9-11, 1983. The Organizing Com mittee consisted of Drs. Diana Anderson (BIBRA), Robert Haynes (York University), Bernard Kunz (NIEHS), Barry Glickman (NIEHS), and Frederick J. de Serres (NIEHS), Chairman. The meeting was org- ized by the staff of the Office of the Associate Director for Genetics and was financed solely by the National Institute of Environmental Health Sciences. Frederick J. de Serres, Ph.D. Associate Director for Genetics v CONTENTS SECTION I. INTRODUCTION Molecular Mechanisms in Genetic Stability and Change: 1 The Role of Deoxyribonucleotide Pool Balance Robert H. Haynes SECTION II. NUCLEOTIDE METABOLISM 25 Metabolic Effects of Poly(ADP-ribose) Inhibitors Kathryn M. Milam and James E. Cleaver Ribonucleotide Reductase and Deoxyribonucleotide 33 POQ 1 s ............................................ . Peter Reichard 47 Enzymatic Channeling of DNA Precursors Christopher K. Mathews A Possible Secondary Role for Thymine-Containing DNA 67 Precursors ....................................... . Robert J. Melamede and Susan S. Wallace Multiple Mechanisms of Adenosine Toxicity in an Adenosine Sensitive Mutant of Baby Hamster 103 Kidney (BHK) Cells ............................... ."